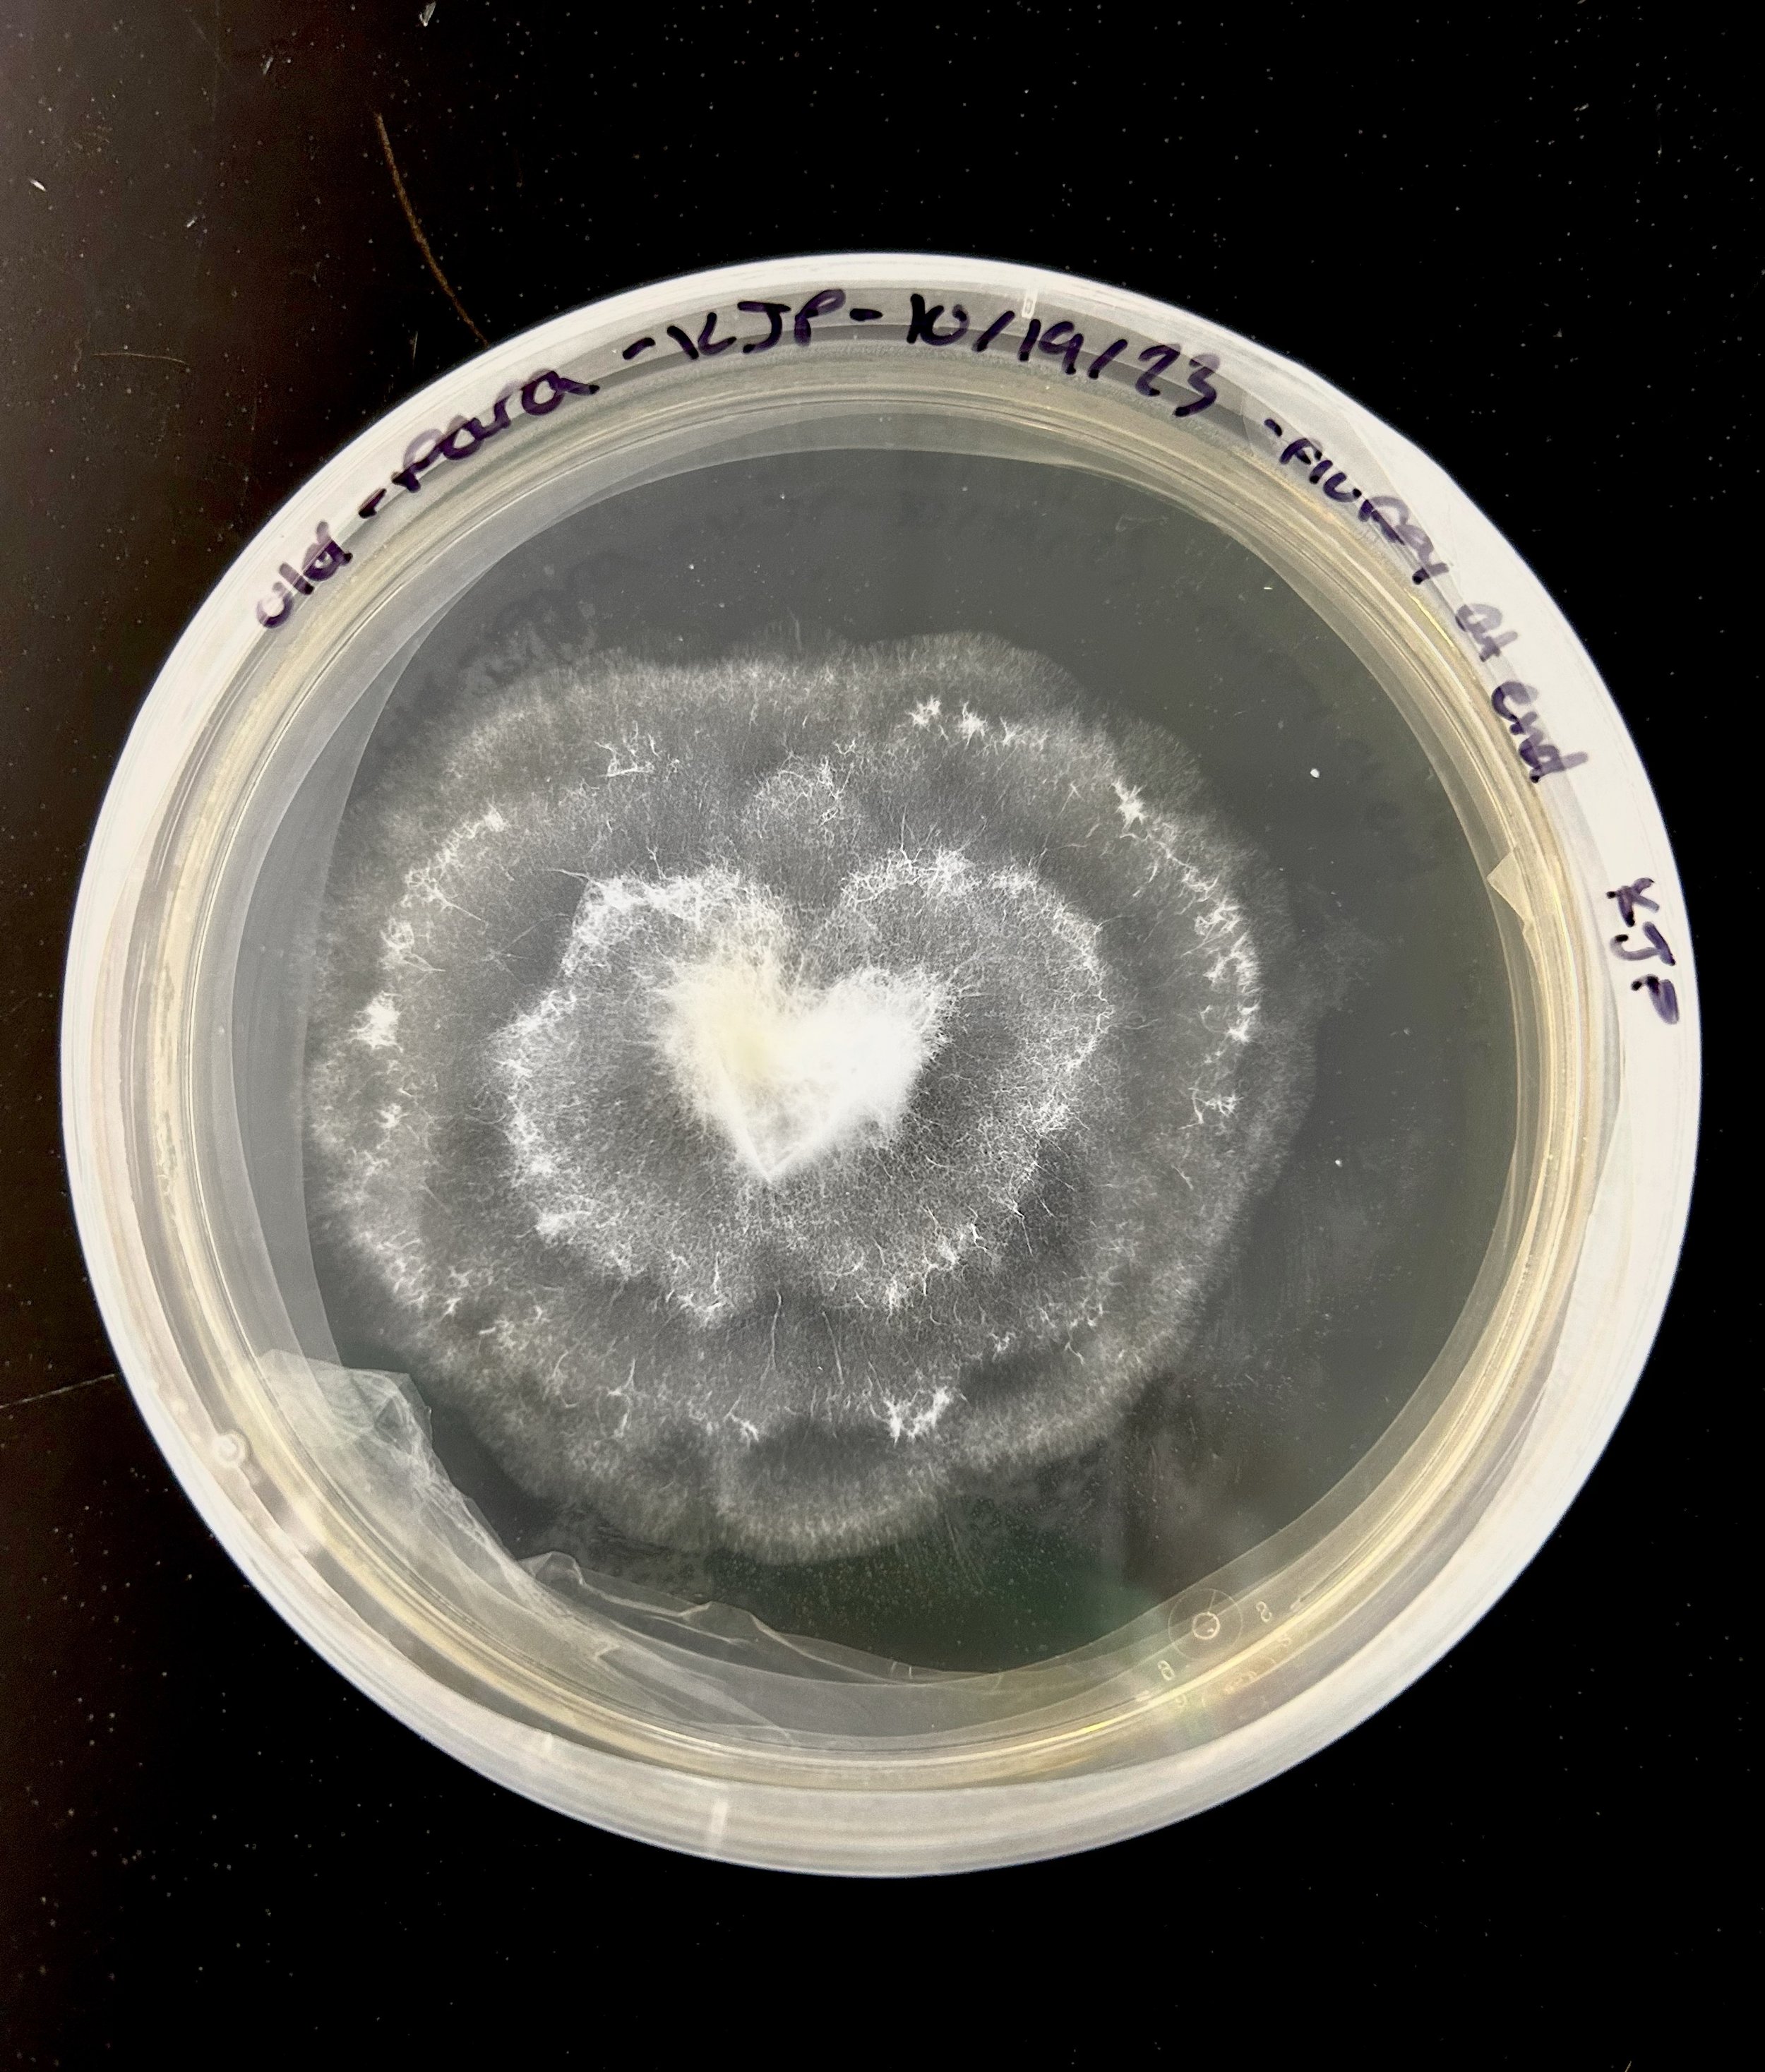
Heart-Shaped Fungus

Secret Garden
2023-2024
Some Type of Regret
By Violet Russell
By Violet Russell
A hound dog gnaws on my
funny bone and I can feel
ravines wash down those
calloused cowhide hands
It’s a painful twist of fate
a Dundee knife vexing the
soft spot of my inner thigh
Choke down some ibuprofen
a clown smiles hello in the
overflown sink—it’s gotta be
plugged up with some type
of regret—chunks of ground
pork and red thumbtacks
and it goes churning ‘round
my washing machine stomach
I wish it would all just stop
Bubbles of hysteria work up
through my lungs—I can taste
my rancid laughter before it
pops from my lips
Abandona Puesto
By Saint
By Saint
Espero que implosione,
Allá en lo hondo,
Y en tus últimos momentos
Mis manos en tu cuello,
Agua llenando el vacío.
¿Acaso no te acuerdas?
Cuando la llovizna cubría
Nuestras caras,
Sudor en la frente.
La última vez que me viste,
Sentados en mi cama,
Ya sabias que te irías
A lo profundo.
Abandona puesto,
Y al final,
¿Que has echo
Con lo que palpitaba
Dentro de mi?
- Dentro de mi pecho?
The Vivisection
By Jameson Gillihan
By Jameson Gillihan
When I met the doctor, thinking nothing wrong,
He promptly diagnosed me. There was something wrong.
Let me feel your heartbeat, he said, let me hear its hum—
Recognize the reticent resounding of its drum—
Shouldn’t it seem stronger? Shouldn’t we hear more?
Are you unfamiliar with the rhythm of your core?
I have the solution. Put your trust in me;
Correct your constitution and you’ll be who you should be.
Well, harm me handsome, doctor. Make me work like new.
Help my heart to do the things the heart is here to do.
I signed the consent form. He wasted not a beat
and set a surgeon’s date night with the heart he hoped to meet.
Feeling all aflutter, I anesthetized myself
and woke up bruised and bloody on the path to perfect health.
I received instructions from the doctor for my care.
I made no deductions of the doctor or his care.
He wrote I may manifest some pulse- or piercing pain,
that healing’s halfway mental, that something in the brain
would have to intertwine the old nerves in between the new—
through this agonizing process, my heart would be debuted.
Time passes so slowly.
I couldn’t wait.
I had been so
wholly
impatient.
I couldn’t take it.
I needed pain.
I needed to know this all wasn’t in vain.
Invested in this injury as proof that I had changed,
I dressed in scrubs and surgeon’s gloves to operate again.
Sharpening my scalpel, I carved into my chest,
I opened, operating, I was bleeding, I was bled—
The wound unfolded freely, the blade I barely felt;
The place he’d cut to cure me was the place I cut myself.
Perhaps this was my treatment.
Perhaps I’m built for pain.
Perhaps what hurt me once gave me the means to hurt again.
Now I was left wanting. I spindled strands of vein
to part the chains imprisoning the precious flesh he’d saved;
Squeezing fists of viscera, I squinted to compare
this body with the one I’d been before the doctor’s care.
Would I know the difference? What was there to find
behind the ribs I pried apart to witness his design?
I grasped it in my fingers. I pulled it from my chest
and freed the famished muscle from my penitential breast.
Rich and ripe for harvest, ravenous and raw,
the organ oozing in my grip hitched wide its dripping maw.
I recognized it readily. This heart—
It was wrong.
This heart I knew at once though I had never known my own—
This heart—
It hungered.
This heart beheld a feast.
In my palm pulsed the surgeon’s heart—
Finally released.